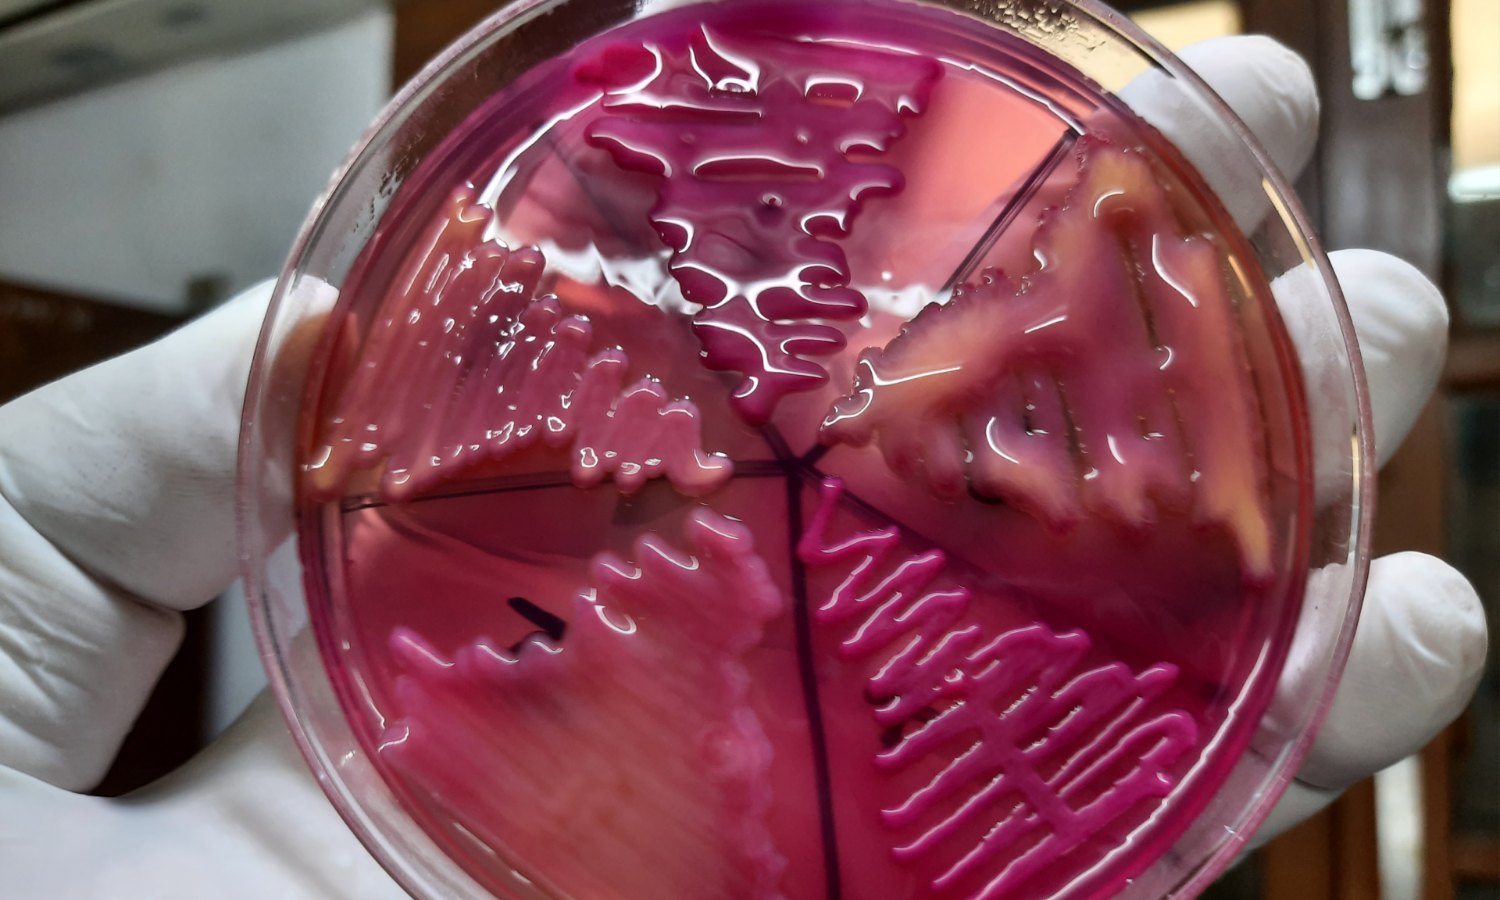

Bakterija klebsiella u urinu jedan je od značajnih uzročnika infekcija mokraćnih puteva, koje spadaju među najčešće bakterijske infekcije kod odraslih, naročito žena.
Najpoznatija vrsta, klebsiella pneumoniae, prirodno se nalazi u crevima i respiratornom traktu, ali ulaskom u bešiku ili bubrege može izazvati ozbiljnu upalu.
Simptomi obično uključuju učestalo i bolno mokrenje, peckanje, mutan ili neprijatan miris urina, bol u donjem stomaku ili leđima, a u težim slučajevima i povišenu temperaturu.
Lečenje infekcije klebsiella bakterijom zasniva se na primeni antibiotika prema nalazu urinokulture i antibiograma, uz simptomatsku terapiju i povećan unos tečnosti.
Značajan izazov u lečenju predstavlja porast sojeva otpornih na više antibiotika, uključujući i karbapeneme, što takve sojeve svrstava u takozvane superbakterije.
U ovom članku objasnićemo šta znači prisustvo klebsiella bakterije u urinu, kako ona dospeva u urinarni trakt, kao i da li je prenosiva, kako izgleda dijagnostika, lečenje i prevencija infekcije.
Šta je klebsiella?
Klebsiella je rod gram-negativnih bakterija iz porodice enterobacteriaceae.
Najčešće izolovana vrsta je klebsiella pneumoniae, a značajna je i klebsiella oxytoca, dok se ređe sreću vrste klebsiella aerogenes i klebsiella terrigena.
Sve ove bakterije imaju oblik štapića i obavijene su spoljašnjom kapsulom koja im omogućava da se zaštite od imunog sistema domaćina.
Klebsiella se prirodno nalazi u crevima i na sluzokoži respiratornog trakta zdravih osoba, gde obično ne izaziva tegobe.
Ipak, klebsiella pneumoniae je posebno poznata kao čest uzročnik upale pluća, a može dovesti i do infekcija mokraćnih puteva, rana i krvi.
Izazov kod lečenja infekcija izazvanih ovom bakterijom predstavlja sposobnost pojedinih sojeva da proizvode enzime poput beta-laktamaza i karbapenemaza.
Ovi enzimi razgrađuju peniciline, cefalosporine i čak karbapeneme, zbog čega sojevi postaju višestruko otporni na antibiotike i posebno značajni u kontekstu bolničkih infekcija.
Kako klebsiella dospeva u urinarni trakt?
Najčešći put ulaska bakterije klebsiella u urinarni trakt jeste prelazak iz spoljašnjeg predela u uretru, odakle se širi ka bešici.
Bakterija koja prirodno živi u crevima može preći u uretru, naročito kod žena zbog blizine analnog i vaginalnog otvora, a zatim se proširiti do bešike, slično drugim bakterijama kao što je Escherichia coli, koja je najčešći uzročnik urinarnih infekcija.
Nepravilno brisanje nakon mokrenja, kada se pokret obavlja od nazad ka napred, olakšava prenošenje bakterija iz analnog područja u uretru i bešiku.
Kada klebsiella dospe u bešiku, toplo i vlažno okruženje pogoduje njenom razmnožavanju, pa se razvija upala bešike poznata kao cistitis.
Ako se cistitis ne prepozna i ne leči na vreme, infekcija može napredovati kroz mokraćne kanale do bubrega i izazvati pijelonefritis, upalu bubrega.
Ukoliko dođe do upale bubrega, simptomi mogu biti intenzivniji, uključujući visoku temperaturu i izražene znake opšte bolesti.
U ređim slučajevima, klebsiella može proći u krvotok i izazvati bakterijemiju, a u težim okolnostima i sepsu.
Da li je klebsiella prenosiva?
Klebsiella pneumoniae se ne širi vazduhom kao respiratorni virusi, već se prenosi direktnim kontaktom, seksualnim odnosom, poljupcem ili preko kontaminiranih površina i predmeta.
Najčešći put prenosa je u bolničkim uslovima, gde nepoštovanje higijenskih mera omogućava da bakterija pređe sa ruku ili medicinske opreme na drugog pacijenta.
Tako se infekcija može preneti sa osobe na osobu, naročito kod onih sa oslabljenim imunitetom ili postavljenim kateterima.
U svakodnevnim uslovima, klebsiella uglavnom ne predstavlja rizik za zdrave osobe, ali kod hospitalizovanih i pacijenata sa hroničnim bolestima može izazvati ozbiljne infekcije.
Redovno pranje ruku, korišćenje kondoma i dezinfekcija površina su ključne mere za smanjenje rizika širenja bakterije.
Simptomi
Infekcije mokraćnih puteva izazvane bakterijom klebsiella mogu izazvati različite simptome, u zavisnosti od toga da li je zahvaćena bešika, bubrezi ili čak krvotok.
Najčešće se u ranim fazama infekcija javljaju znaci upale donjeg dela mokraćnog sistema, kao što su:
- Peckanje ili bol tokom mokrenja
- Učestala ili hitna potreba za mokrenjem, uz izlučivanje male količine urina
- Bol u donjem delu stomaka, u predelu bešike, ili bol u donjem delu leđa, u predelu bubrega
- Promene u mokraći kao što su mutan ili taman urin, neprijatan miris ili prisustvo krvi
- Povišena telesna temperatura i osećaj opšte malaksalosti
Ovakvi simptomi najčešće ukazuju na cistitis, odnosno upalu bešike, no kada infekcija napreduje do bubrega i razvije se pijelonefritis, tegobe postaju ozbiljnije.
Simptomi upale bubrega uključuju visoku temperaturu, groznicu, mučninu, povraćanje i izražen bol u bubrezima.
U najtežim slučajevima bakterija može ući u krvotok i izazvati sepsu, stanje koje se prepoznaje po intenzivnoj drhtavici, ubrzanom radu srca, padu krvnog pritiska i poremećaju svesti.
Sepsa je stanje koje je opasno po život, i zahteva hitnu medicinsku intervenciju, te u slučaju da postoji sumnja na ovo stanje, neophodno je neodložno javljanje lekaru koji će proceniti stanje uz pomoć analiza krvi i markera upale, kao što su CRP i PCT u krvi.
Na kraju, treba naglasiti da trudnice, starije osobe i pacijenti sa oslabljenim imunitetom ponekad mogu imati prisustvo klebsiella bakterije u urinu bez jasnih simptoma, pa su redovne analize urina posebno značajne, jer i asimptomatska infekcija može zahtevati terapiju radi sprečavanja komplikacija.
Faktori rizika
Razvoj infekcije bakterijom klebsiella u urinarnom traktu ne zavisi samo od prisustva mikroorganizma, već i od različitih predisponirajućih faktora.
Određene grupe ljudi imaju znatno veću verovatnoću da obole zbog anatomskih, fizioloških ili imunoloških razloga, kao i zbog uticaja spoljašnjih faktora.
Faktori rizika za razvoj infekcije bakterijom klebsiella uključuju:
- Ženski pol: Kod žena su analno i genitalno područje blizu, a mokraćna cev kraća, što bakterijama olakšava prodor u urinarni trakt.
- Trudnoća: Pritisak rastuće materice na mokraćne kanale otežava potpuno pražnjenje bešike i stvara povoljne uslove za infekciju.
- Urinarnu kateterizaciju: Prisustvo katetera predstavlja direktan kanal za ulazak bakterija u bešiku.
- Uvećana prostata: Kod starijih muškaraca uvećana prostata usporava protok mokraće i dovodi do njenog zadržavanja, što pogoduje razvoju bakterija.
- Dijabetes: Povišen šećer u mokraći i oslabljena odbrana organizma olakšavaju razmnožavanje klebsiella bakterija.
- Anatomske prepreke: Kamen u bubregu ili urođene anomalije urinarnog sistema ometaju normalan protok mokraće i povećavaju rizik od infekcije.
- Oslabljen imunitet: Osobe sa imunodeficijencijama, hroničnim bolestima ili pod imunosupresivnom terapijom imaju slabiju odbranu od bakterija.
- Starost: Stariji ljudi prirodno imaju slabiji imuni sistem i češće pridružene bolesti koje doprinose učestalijim infekcijama.
- Bolnička nega: Dugotrajno lečenje u bolnici, naročito na intenzivnoj nezi, i prethodna upotreba jakih antibiotika povećavaju rizik od infekcije multirezistentnim sojevima.
- Deca: Kod novorođenčadi nezreo imuni sistem i boravak u porodilištu mogu pogodovati pojavi infekcije.
Dijagnostika
Dijagnoza infekcije urinarnih puteva izazvane bakterijom klebsiella postavlja se laboratorijskim analizama urina.
Prvi pokazatelj problema može biti osnovna analiza urina, kojom se utvrđuje prisustvo leukocita u urinu, odnosno belih krvnih zrnaca, i nitrita.
Povećan broj leukocita ukazuje na postojanje upale, dok se nitriti pojavljuju jer bakterije, među njima i klebsiella, razgrađuju nitrate iz hrane i pretvaraju ih u nitrite.
Pored leukocita i nitrita, u nalazu osnovne analize mogu se javiti i epitelne ćelije ili hemoglobin u urinu.
Ovi nalazi nisu specifični za infekciju bakterijom Klebsiella, ali mogu ukazivati na oštećenje sluzokože ili prisustvo krvi, pa se uvek tumače u kontekstu kompletne kliničke slike.
Ako analiza urina ukaže na infekciju, sledeći korak je urinokultura, koja predstavlja najpouzdaniji metod za potvrđivanje infekcije bakterijom klebsiella.
Urinokultura predstavlja postupak tokom kog se uzorak urina, najčešće srednjim mlazom u sterilnoj posudi, stavlja na hranljive podloge u laboratoriji i ostavlja da se inkubira.
Nakon rasta kolonija, one se broje, a rezultat se izražava u kolonijama po mililitru urina.
Nalaz iznad 100.000 kolonija u jednom mililitru najčešće potvrđuje infekciju, iako se i manji brojevi mogu smatrati značajnim ako pacijent ima izražene simptome.
Istovremeno se radi antibiogram, koji pokazuje osetljivost izolovane bakterije na različite antibiotike.
Mikroskopski pregled sedimenta urina takođe može pokazati povišen broj leukocita i prisustvo bakterija.
Kod sumnje na komplikovane ili ponovljene infekcije, lekar može uputiti na dodatne pretrage.
Ultrazvuk bubrega i bešike koristi se za otkrivanje kamena ili prepreka u mokraćnim putevima, dok cistoskopija, pregled unutrašnjosti bešike endoskopom, može pomoći u otkrivanju promena na sluzokoži poput polipa, tumora ili striktura koje se ne uočavaju drugim metodama.
Lečenje
Infekcije mokraćnih puteva izazvane bakterijom klebsiella zahtevaju pažljivo odabranu terapiju, jer ova bakterija može biti prirodno otporna na pojedine antibiotike i razvijati dodatne mehanizme rezistencije.
Nakon što se u uzorku urina potvrdi prisustvo klebsiella pneumoniae i utvrdi antibiogram izolata, bira se lek na koji je soj osetljiv.
Ampicilin se, na primer, ne koristi jer je klebsiella prirodno rezistentna na njega.
Umesto toga, za lečenje klebsiella infekcije mogu se koristiti antibiotici kao što su:
- Nitrofurantoin ili fosfomicin: Koriste se kod nekomplikovanih infekcija bešike, jer se nakupljaju u mokraći i efikasno deluju direktno u urinarnom traktu.
- Cefalosporini ili fluorohinoloni: Cefuroksim i ciprofloksacin primenjuju se kod umerenih i težih infekcija, naročito kada je upala zahvatila i bubrege.
- Trimetoprim-sulfametoksazol: Lekovi kao što je Bactrim su potencijalni lek izbora ako antibiogram pokaže osetljivost, iako je otpornost na ovaj lek danas sve češća.
- Aminoglikozidi: Gentamicin i slični antibiotici daju se intravenski u bolničkim uslovima kod teških infekcija i sepse, uz oprez zbog mogućeg oštećenja bubrega i sluha.
- Karbapenemi: Ertapenem i meropenem koriste se kao rezervni antibiotici kod infekcija izazvanih multirezistentnim sojevima. Njihova primena zahteva bolnički nadzor i strogu kontrolu.
Trajanje terapije zavisi od težine infekcije.
Kod blažih oblika cistitisa obično traje tri do pet dana, dok kod pijelonefritisa ili sepse lečenje može trajati i nekoliko nedelja.
Važno je da se terapija sprovede do kraja kako bi se infekcija u potpunosti suzbila i smanjio rizik od povratka bolesti.
Pored antibiotika kao osnovnih lekova za urinarne infekcije, preporučuje se unos dovoljno tečnosti radi bržeg ispiranja bakterija mokraćom.
Simptomi poput bola i povišene temperature mogu se ublažiti analgeticima i antipireticima uz savet lekara.
U nekim slučajevima, uz konsultaciju sa lekarom, mogu se uvesti i prirodni preparati kao što su Palisept, Naturoplex, dodaci sa brusnicom ili ulje divljeg origana, koji mogu ubrzati lečenje i oporavak.
Moguće komplikacije
Infekcije mokraćnih puteva izazvane bakterijom klebsiella u većini slučajeva se uspešno leče, ali ukoliko se ne prepoznaju ili adekvatno ne saniraju, mogu dovesti do ozbiljnih posledica.
Neke od najznačajnijih komplikacija su:
- Pijelonefritis: Upala bubrega koja nastaje širenjem infekcije iz bešike. Ako se ne leči pravovremeno, može izazvati trajno oštećenje bubrežnog tkiva.
- Hronični recidivi: Učestale infekcije mokraćnih puteva koje se vraćaju uprkos terapiji. Ponavljani upalni procesi mogu oštetiti sluzokožu mokraćnog sistema i povećati rizik od trajnog oštećenja bubrega.
- Komplikacije u trudnoći: Nelečene infekcije mogu povećati rizik od prevremenog porođaja, niske porođajne težine deteta ili drugih komplikacija tokom trudnoće.
- Prostatitis: Kod muškaraca se infekcija može proširiti na prostatu, što izaziva bol u preponama, otežano mokrenje i groznicu, a zahteva dugotrajniji i specifičan tretman.
- Abscesi: Stvaranje gnojnih džepova u bubrezima ili okolnim tkivima usled neadekvatno lečenih ili ponovljenih infekcija. Ovakva stanja obično zahtevaju drenažu i jaku antibiotsku terapiju.
- Sepsa: Sekundarna bakterijemija izazvana klebsiellom može brzo dovesti do sepse, što je stanje opasno po život koje zahteva intenzivnu medicinsku negu.
Prevencija
Prevencija infekcija mokraćnih puteva izazvanih bakterijom klebsiella zasniva se na svakodnevnim higijenskim navikama, pravilnom načinu života i odgovornom korišćenju antibiotika.
Ove mere doprinose smanjenju rizika od nastanka infekcije i pojave rezistentnih sojeva.
Prevencija urinarnih infekcija, uključujući i one izazvane bakterijom klebsiella, uključuju mere kao što su:
- Hidratacija: Redovan unos dovoljne količine vode pomaže ispiranju bakterija iz urinarnog trakta.
- Redovno pražnjenje bešike: Dugo zadržavanje mokraće povećava rizik od infekcije jer stajaća mokraća pogoduje razmnožavanju bakterija.
- Higijena: Održavanje dobre higijene genitalnog područja, pranje čistom vodom i blagim sapunom, kao i brisanje od napred ka nazad nakon toaleta smanjuju rizik od prenosa bakterija.
- Izbegavanje iritansa: Parfimisani sapuni, gelovi i drugi agresivni proizvodi mogu iritirati urinarni trakt i olakšati nastanak infekcije.
- Odgovarajuća odeća: Pamučno donje rublje i izbegavanje tesne odeće održavaju genitalno područje suvim i smanjuju rizik od infekcije.
- Pažljivo korišćenje katetera: Kada je kateter neophodan, mora se koristiti uz strogo poštovanje higijenskih pravila i redovnu zamenu opreme.
- Odgovorna upotreba antibiotika: Antibiotike treba uzimati samo po preporuci lekara i završiti ceo propisani tretman kako bi se sprečila pojava rezistentnih sojeva.
Zaključak
Klebsiella u urinu predstavlja čest uzrok urinarnih infekcija koje nastaju prelaskom bakterije u uretru i bešiku.
Infekcije bakterijom klebsiella se češće javljaju kod osoba sa anatomskim i funkcionalnim predispozicijama, kateterom, dijabetesom, oslabljenim imunitetom ili tokom bolničke nege.
Lečenje infekcije podrazumeva ciljanu primenu antibiotika prema osetljivosti utvrđenoj antibiogramom, uz simptomatske mere i adekvatan unos tečnosti.